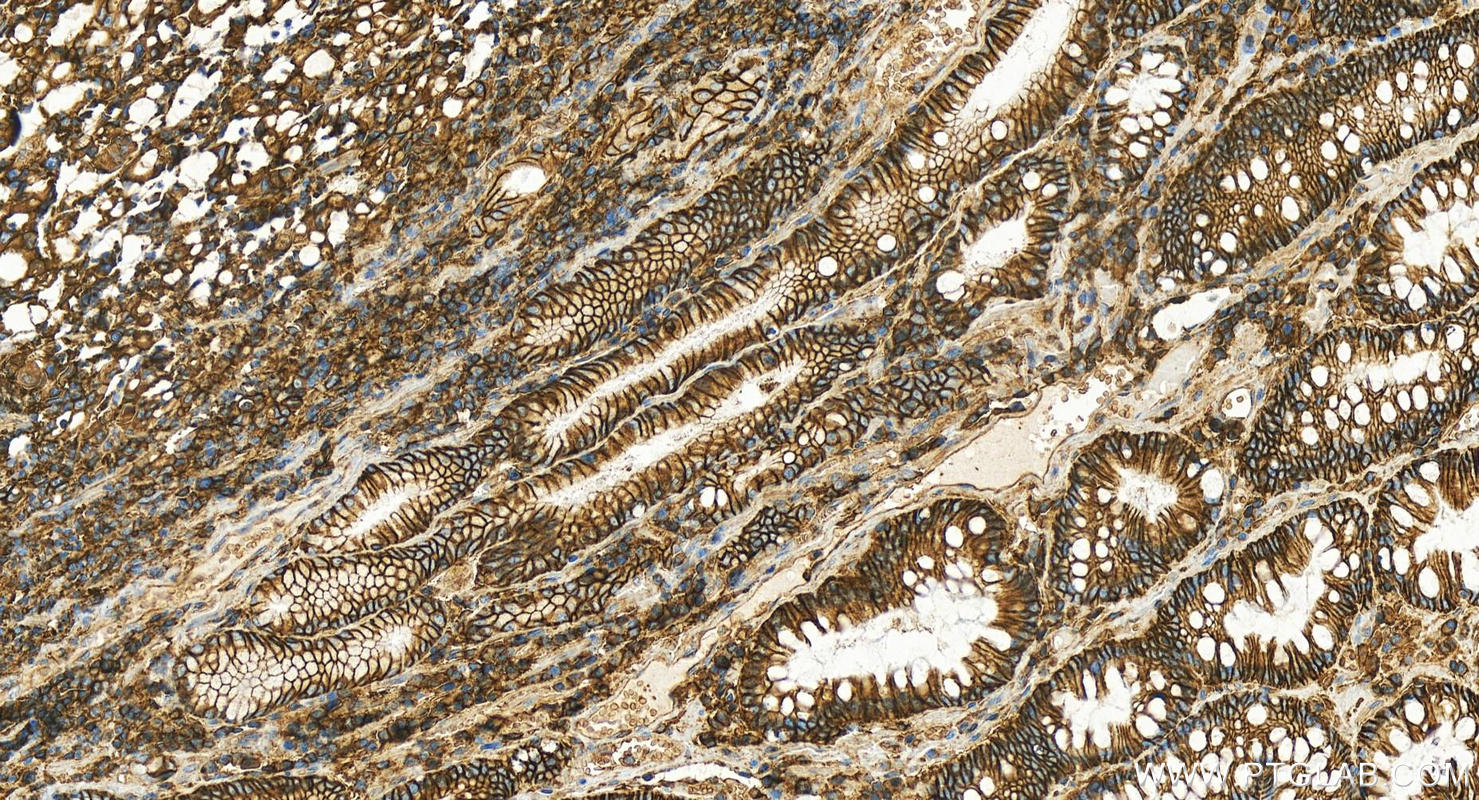

验证数据展示
经过测试的应用
| Positive WB detected in | HeLa cells, human liver tissue, Jurkat cells, mouse heart tissue, mouse liver tissue, HepG2 cells |
| Positive IP detected in | HEK-293 cells |
| Positive IHC detected in | human stomach cancer tissue, human liver cancer tissue, human lung cancer tissue Note: suggested antigen retrieval with TE buffer pH 9.0; (*) Alternatively, antigen retrieval may be performed with citrate buffer pH 6.0 |
| Positive IF/ICC detected in | A431 cells, HeLa cells, MCF-7 cells |
推荐稀释比
| 应用 | 推荐稀释比 |
|---|---|
| Western Blot (WB) | WB : 1:5000-1:50000 |
| Immunoprecipitation (IP) | IP : 0.5-4.0 ug for 1.0-3.0 mg of total protein lysate |
| Immunohistochemistry (IHC) | IHC : 1:400-1:1600 |
| Immunofluorescence (IF)/ICC | IF/ICC : 1:50-1:500 |
| It is recommended that this reagent should be titrated in each testing system to obtain optimal results. | |
| Sample-dependent, Check data in validation data gallery. | |
产品信息
11989-1-AP targets CD147 in WB, IHC, IF/ICC, IP, CoIP, ELISA applications and shows reactivity with human, mouse samples.
| 经测试应用 | WB, IHC, IF/ICC, IP, ELISA Application Description |
| 文献引用应用 | WB, IHC, IF, IP, CoIP |
| 经测试反应性 | human, mouse |
| 文献引用反应性 | human, mouse, rat |
| 免疫原 |
CatNo: Ag2619 Product name: Recombinant human CD147 protein Source: e coli.-derived, PGEX-4T Tag: GST Domain: 1-269 aa of BC009040 Sequence: MAAALFVLLGFALLGTHGASGAAGTVFTTVEDLGSKILLTCSLNDSATEVTGHRWLKGGVVLKEDALPGQKTEFKVDSDDQWGEYSCVFLPEPMGTANIQLHGPPRVKAVKSSEHINEGETAMLVCKSESVPPVTDWAWYKITDSEDKALMNGSESRFFVSSSQGRSELHIENLNMEADPGQYRCNGTSSKGSDQAIITLRVRSHLAALWPFLGIVAEVLVLVTIIFIYEKRRKPEDVLDDDDAGSAPLKSSGQHQNDKGKNVRQRNSS 种属同源性预测 |
| 宿主/亚型 | Rabbit / IgG |
| 抗体类别 | Polyclonal |
| 产品类型 | Antibody |
| 全称 | basigin (Ok blood group) |
| 别名 | 5F7, Basigin, BSG, Collagenase stimulatory factor, EMMPRIN |
| 计算分子量 | 385 aa, 42 kDa |
| 观测分子量 | 35-58 kDa |
| GenBank蛋白编号 | BC009040 |
| 基因名称 | CD147 |
| Gene ID (NCBI) | 682 |
| RRID | AB_2290597 |
| 偶联类型 | Unconjugated |
| 形式 | Liquid |
| 纯化方式 | Antigen affinity purification |
| UNIPROT ID | P35613 |
| 储存缓冲液 | PBS with 0.02% sodium azide and 50% glycerol, pH 7.3. |
| 储存条件 | Store at -20°C. Stable for one year after shipment. Aliquoting is unnecessary for -20oC storage. |
背景介绍
CD147, also known as Basigin or extracellular matrix metalloproteinase inducer (EMMPRIN), is a transmembrane glycoprotein that belongs to the immunoglobulin superfamily (PMID: 7812975). The molecule is composed of an intracellular portion and an extracellular portion and a single transmembrane region. CD147 is expressed on a variety of cell types (e.g., hematopoietic, epithelial, and endothelial cells) and at varying levels (PMID: 32968061). Increased expression of CD147 occurs in many tumors. CD147 is a pleiotropic molecule that plays an important role in fetal, neuronal, lymphocyte and extracellular matrix development (PMID: 17945211). CD147 has been identified as a receptor essential for erythrocyte invasion by Plasmodium falciparum (PMID: 22080952). It has been reported that spike protein of SARS-CoV-2 binds to CD147 on host cells, thereby mediating the viral invasion (Wang, Ke, et al, BioRxiv, 2020). The CD147 gene, designated BSG for basigin, is located on chromosome 19p13.3. Four transcript variants encoding different isoforms have been found (PMID: 21536654). CD147 migrates on SDS-PAGE usually between 35 and 65 kDa, depending on the degree of glycosylation (PMID: 17945211).
实验方案
| Product Specific Protocols | |
|---|---|
| IF protocol for CD147 antibody 11989-1-AP | Download protocol |
| IHC protocol for CD147 antibody 11989-1-AP | Download protocol |
| IP protocol for CD147 antibody 11989-1-AP | Download protocol |
| WB protocol for CD147 antibody 11989-1-AP | Download protocol |
| Standard Protocols | |
|---|---|
| Click here to view our Standard Protocols |
发表文章
| Species | Application | Title |
|---|---|---|
Nat Commun Genome-wide screens identify SEL1L as an intracellular rheostat controlling collagen turnover | ||
J Extracell Vesicles Optimized AF4 combined with density cushion ultracentrifugation enables profiling of high-purity human blood extracellular vesicles | ||
J Clin Invest Hypomorphic variants of SEL1L-HRD1 ER-associated degradation are associated with neurodevelopmental disorders | ||
Cell Mol Immunol CD147 deficiency in T cells prevents thymic involution by inhibiting the EMT process in TECs in the presence of TGFβ. | ||
Acta Pharmacol Sin 124I-labeled anti-CD147 antibody for noninvasive detection of CD147-positive pan-cancers: construction and preclinical studies | ||
Elife Erythrocyte invasion-neutralising antibodies prevent Plasmodium falciparum RH5 from binding to basigin-containing membrane protein complexes |